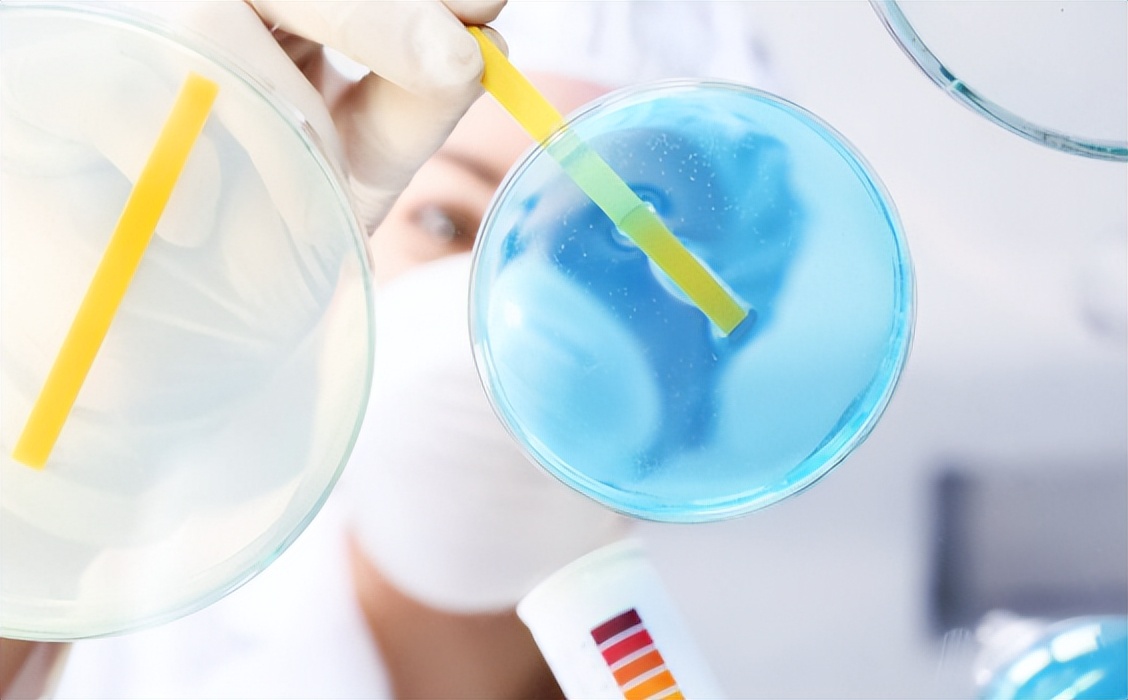
成人每次排便后需要洗屁股吗,便后洗屁股有好处吗

喜欢多多分享一下,点赞收藏评论加“关注”是我持续更新的动力,感谢您的支持。
生活中,很多人都有便后水洗屁股的习惯,认为这样十分的干净可以更好的去除未能清洁的细菌和粪便,小刘就是其中一位。

小刘在早期的时候,小刘也并没有这个习惯,但是他每次在清洗*裤内**的时候都会发现很多微小的粪迹这让他感觉十分的恶心,并且觉得这样十分的不卫生。
同时, 小刘还感觉经常会出现瘙痒,不舒服等症状, 于是他为了更好的进行卫生清洁,开始在每次便后进行清洗。
并且有的时候还会选择用盐水加入来进行清洗,认为这样才可以更好的起到杀菌彻底的作用。

大便之后是否需要洗屁股
其实专家建议还是很有必要的,这是因为单单用纸巾进行清理并不能很好的起到清洁的作用。
因为纸巾在进行擦拭的过程中很难完全彻底的清洁粪便区域同时还会残留大量的细菌,这样就会造成细菌的堆积与滋生,久而久之就会危害肛门健康。
另外如果过于频繁的用纸巾进行反复擦拭,还会起到适得其反的作用,不仅不能进一步进行清理还会使其损伤皮肤, 频繁的刺激摩擦,造成肛门的干燥,进而出现出血等问题发生。

与此同时还会由于纸巾的质量问题残留在肛门内部,都会加重自身的不适感和细菌的滋生,严重危害使用者的自身健康。
同时如果长时间不清理干净肛门还会使其出现痔疮等一系列疾病,对于肛门健康十分不利,所以在便后进行清洗屁股是极为必要的。
长期坚持洗的益处
那么在知道了清洗屁股的重要性之后,我们是否需要长时间坚持清洗呢?如果坚持清洗又会产生什么益处呢?
其实主要是以下四大点,分别是 加速臀部的血液循环,避免肛门部位出现感染,预防各种疾病的产生,缓解痔疮症状。

1、加速血液循环
在生活中,很多时候都有人长时间进行久坐,不锻炼的习惯,当长时间如此,会对盆部肌肉造成很大的压力和紧张状态,造成其出现血液的不循环,且会出现血管的堵塞以及其他的相关问题。
另外,人体的臀部及其动相对较差,并且常处于固定不动的状态, 血液循环能力进一步降低,进而危害身体健康 ,出现相关的病症。

特别是对于部分人患有痔疮或者便秘等情况的患者,在上厕所时经常会长时间处于深蹲状态,对于盆部肌肉的循环进一步出现阻碍。
因此在便后进行适当的清洗,可以在一定程度上起到按摩的作用 ,帮助盆部肌肉进行更好的血液循环,促进其进行血液流动。
还可以保证肛周的健康,保持周边肌肉的稳定和活性,对于自身健康十分有益。

2、保持肛门洁净
其实在便后用水清洗屁股最为关键的作用就是可以很好的保持肛门的洁净 。
我们都知道,人体的肛门虽然相对较小,但是由于其位置相对隐蔽,同时表面有很多凹凸不平的褶皱,难以通过正常的纸巾将其完全擦拭,所以很容易出现细菌堆积繁殖的情况出现。
因此在便后用清水进行清理,是为了可以更好的帮助其进行洁净,将其表面褶皱部分所藏的细菌以及粪便都可以很好的进行清除, 减少相关细菌病毒的产生和蔓延。
采用清水清洗过屁股后,也会感觉更加的清爽干净,在日常生活中也会觉得更加舒适,请避免了细菌病毒的感染与不适症状,同时还可以减少瘙痒等问题。

3、预防相关疾病
在便后进行清洗屁股还可以很好的预防很多相关疾病,其中最为主要的就是女性的妇科疾病。
我们都知道,女性的生殖器官相对于男性而言,其更加复杂,构成更加多样。
如果在便后没有及时的清理,会将残余的粪便对于自身产生一定的危害,会造成细菌的感染等问题。
特别是对于部分女性处于月经期间时,如果粪便没有清除干净,很容易会出现细菌感染,进而危害月经,以及自身。
所以在来例假期间,更应该注意好便后的清洁工作,从根源上将其清理干净,避免细菌滋生与感染。
落实好自身清洁工作,更好的保证月经期的妇科健康问题,这样可以大大的降低相关妇科疾病的产生。

4、缓解痔疮问题
最后,在便后进行清理工作,可以更好的缓解患者出现痔疮等问题。
根据专家的研究发现,当前患有这种疾病的相关人群十分广泛,而且逐渐出现年轻化和广泛化,很多年轻人由于不正确的生活习惯以及上厕所的习惯,都会严重影响正常的代谢。
同时,现在很多人都有在上厕所时玩手机的习惯,因此就会在一定程度上延长上厕所时间,久而久之出现痔疮等问题。

对于部分患有痔疮的患者而言,在便后很难通过正常的清洁工作来清理,会出现细菌病毒的残留,久而久之危害自身健康。
另外还可以在一定程度上加重痔疮的症状,使其进一步发展病情出现恶化, 因此在病后进行相关的清理工作,对于缓解痔疮问题,治疗痔疮都是极为重要和关键的 。
通过将相关部位清除干净,减少粪便以及细菌的清留,都可以很好的缓解痔疮问题。

便后的注意事项有哪些
那么,除了在病后进行清理外,病后还需要注意哪些事项呢?
其实主要是以下四大点,分别是选择湿纸巾的选择,在清洁时注意水温的控制、纸巾擦拭顺序和清理次数,这些对于肛门健康都十分重要。
1、选用湿纸巾
在生活中,很多人会出现使用湿纸巾来代替纸巾进行便后擦拭的情况。
这是因为湿纸巾相对于纸巾而言,其更具湿润度,可以更好的对于肛门进行有效的擦拭和清理, 同时湿纸巾更具柔软性,避免反复擦拭,造成皮肤的干燥破损等问题。

湿纸巾最为关键的一个优势就是其更加方便,对于在外不方便进行及时清理的人而言,可以选择用湿纸巾进行擦拭,这样既可以起到清洁目的,还可以更方便操作。
同时,对于部分女性想要更好的进行清理,可以选择妇科专用的清洁湿巾, 有效清除表面细菌粪便的残留,同时还起到消炎的作用 ,一举两得。
但是在使用的过程中,一定要注意擦拭顺序,不要将其擦拭其他部位,以免出现感染等问题。

2、清洗水温的控制
第二就是要注意水温的控制,这里的水温是指部分人群选择在便后进行清水清理时,水温是极为关键的。
在生活中,水温不要过高,也不要过低。当水温过低时,会出现过度刺激,造成肌肉迅速受刺激,收缩并不利于自身健康。
同时,对于部分处于经期的女性而言, 并不适宜用凉水进行清理,否则还会危害自身健康 。

另外也不应该过度极端选择温度过高的水,当水温过高时,也会对身体皮肤起到刺激,出现烫伤以及其他相关问题。
对于女性而言,皮肤相对娇嫩,如果用过烫的开水进行冲洗时,很有可能会造成其皮肤的损伤,因此,需要格外注意。
在生活中最好选择适量的温水来进行清理,做到既可以促进身体的血液循环,同时还可以起到清洁洁净的作用。

3、擦拭顺序
最后,对于在便后进行清洗擦拭顺序也有很大的注意事项,在进行擦拭时, 尽量选择从前至后的擦拭方法 ,这样可以更好的避免将后方的粪便细菌带到前面来,从根源上保证干净。
在日常生活中很多人都有从前至后的擦拭方法,这个方法是极为错误的,因为我们都知道肛门在后方,在进行粪便的擦拭时,如果从后往前,很容易将粪便以及其他的细菌等杂质通过擦拭的过程中带到前方。
从而感染前方阴道健康,对于自身保护极为不利, 所以要养成健康的擦拭方式,做到从前往后缓慢擦拭,更好的做到清洁和保证。

4、清洁次数
另外,需要提醒的是,在生活中一定要注意清洁次数。
很多人在了解了便后清理的重要性之后,为了从根本上保证自身健康,减少细菌病毒的滋生,通常会在进行小便后也进行清洗,也就是通常会出现一天清洗多次,反复清洗的现象,但是专家指出,这种方式也是极为错误的。
因为当过于频繁的清洗后可能会出现适得其反的效果,不仅难以起到卫生,同时还会危害自身健康。
这是因为我们人体部位是存在一定的恒定状况的,其内部分泌的相关物质对于防护自身有很强的作用, 当如果过于频繁的进行清理,会将其破坏酸碱度,继而失去相关保护屏障。
这对于维持自身的健康和酸碱平衡极为不利,所以在生活中一定要控制好其清洁次数,只需要在便后进行清理即可,或者是早晚各一次做一次即可,不要频繁多次进行清洗。

结语
综上所述,我们可以了解到,对于肛门健康是极为关键的,在日常生活中最好养成便后及时清洗屁股的习惯,这不仅有利于清洁,同时可以更好的保证自身健康,避免相关疾病的产生。

对于其是否可以长时间进行清洗而言,专家指出,这是一个很好的习惯,可以坚持在便后进行清洗。
另外在长时间坚持便后清洗,可以很好的做到清洁肛门的作用,还可以在一定程度上锻炼臀部肌肉,预防妇科疾病,防止其出现痔疮等问题,帮助身体进行血液循环,更好的进行肛门健康与自身健康。
但是在生活中进行清洗时,也有很多的注意事项,一个是要注意清洗的顺序,同时对于清洗的次数和水温的选择也是十分关键的。

需要提醒广大朋友的是,在生活中不单单应该关注清洗来保证肛门健康, 更需要做到健康饮食和规律作息进行适当的锻炼。
从根本上改变生活习惯,真正做到保证自身健康,同时也要养成良好的上厕所习惯,不要过长时间上厕所,以免出现痔疮等问题。